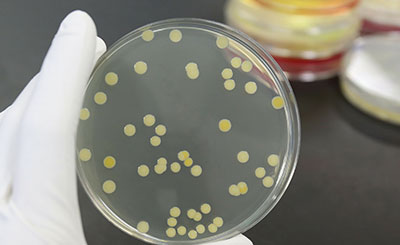

关于我们

华析科技有限公司总部位于苏州,是一家集 材料化工,生物,环境,医药等多个领领域专业的综合型科技服务商。为客户提供全方位的分析、检测、测试、研究开发、法规咨询等技术服务。
自成立以来,华析一直秉承从创新的技术出发,提供从认证到检测、分析与研发等多样性的服务,与多家科研院所,及国内众多知名的检测公司进行深度合作,力争为客户创造更大价值!
华析拥有强大的仪器平台和数据库,多年行业经验的技术团队
-

热分析/红外分析实验室
-

气相实验室
-

理化分析实验室
-

扫描电镜实验室
-

色谱实验室

 高分子领域
高分子领域 精细化学品
精细化学品 化妆及消毒品
化妆及消毒品 环境检测
环境检测 生物医药
生物医药 金属领域
金属领域 食品领域
食品领域 热门行业
热门行业 我们的服务
我们的服务